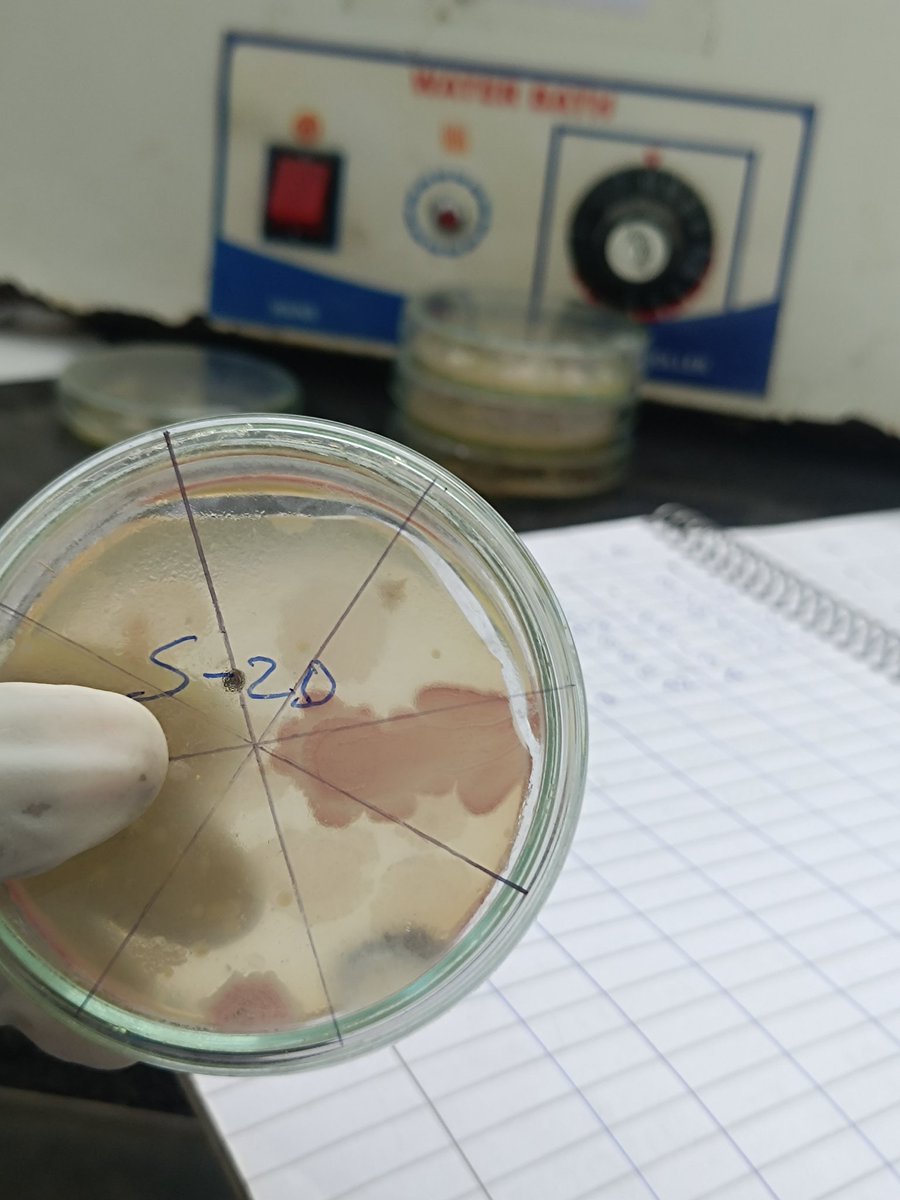
JishuHaldar2's tweet image. Spending my day in the lab, working on my final year project. Slow and steady progress—but it&apos;s happening! #PharmacyLife #LabDiaries #ResearchModeOn
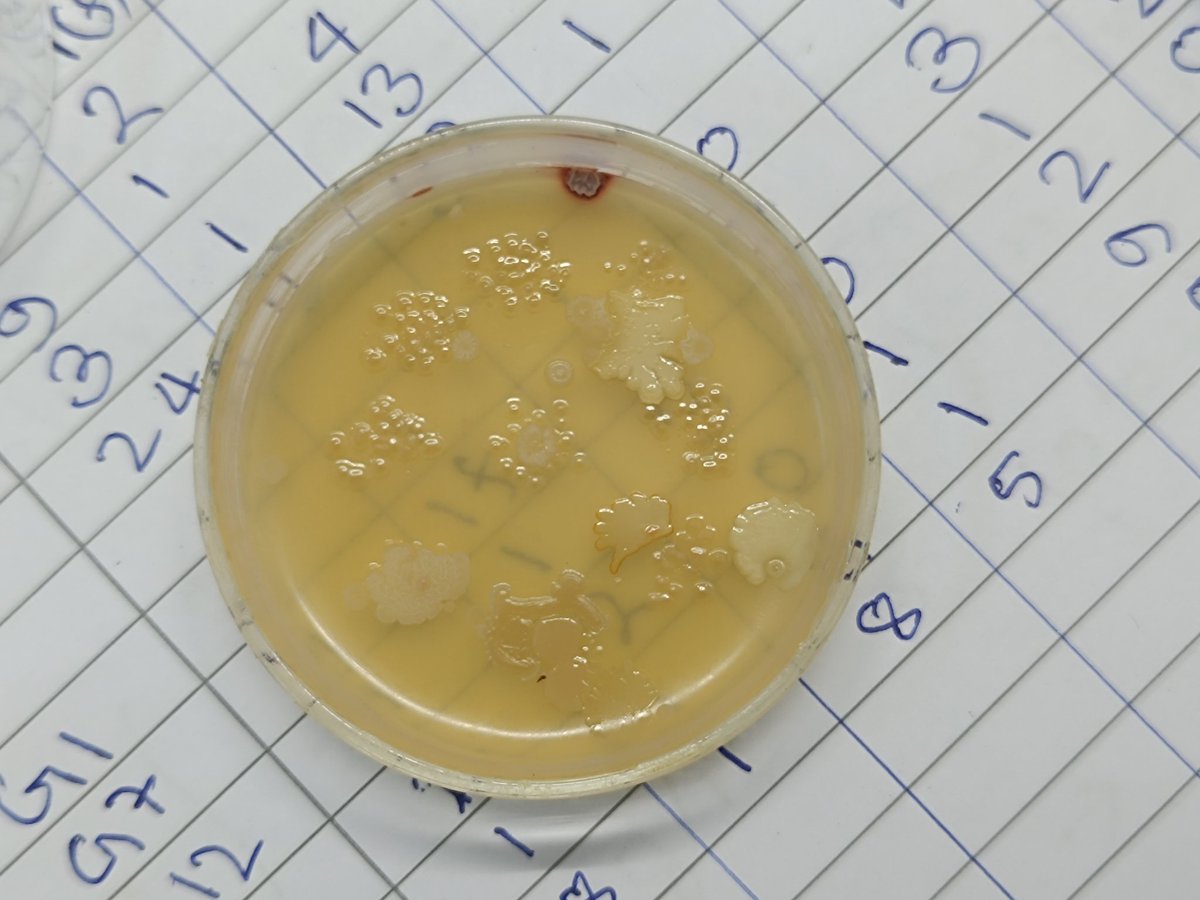
JishuHaldar2's tweet image. Spending my day in the lab, working on my final year project. Slow and steady progress—but it&apos;s happening! #PharmacyLife #LabDiaries #ResearchModeOn
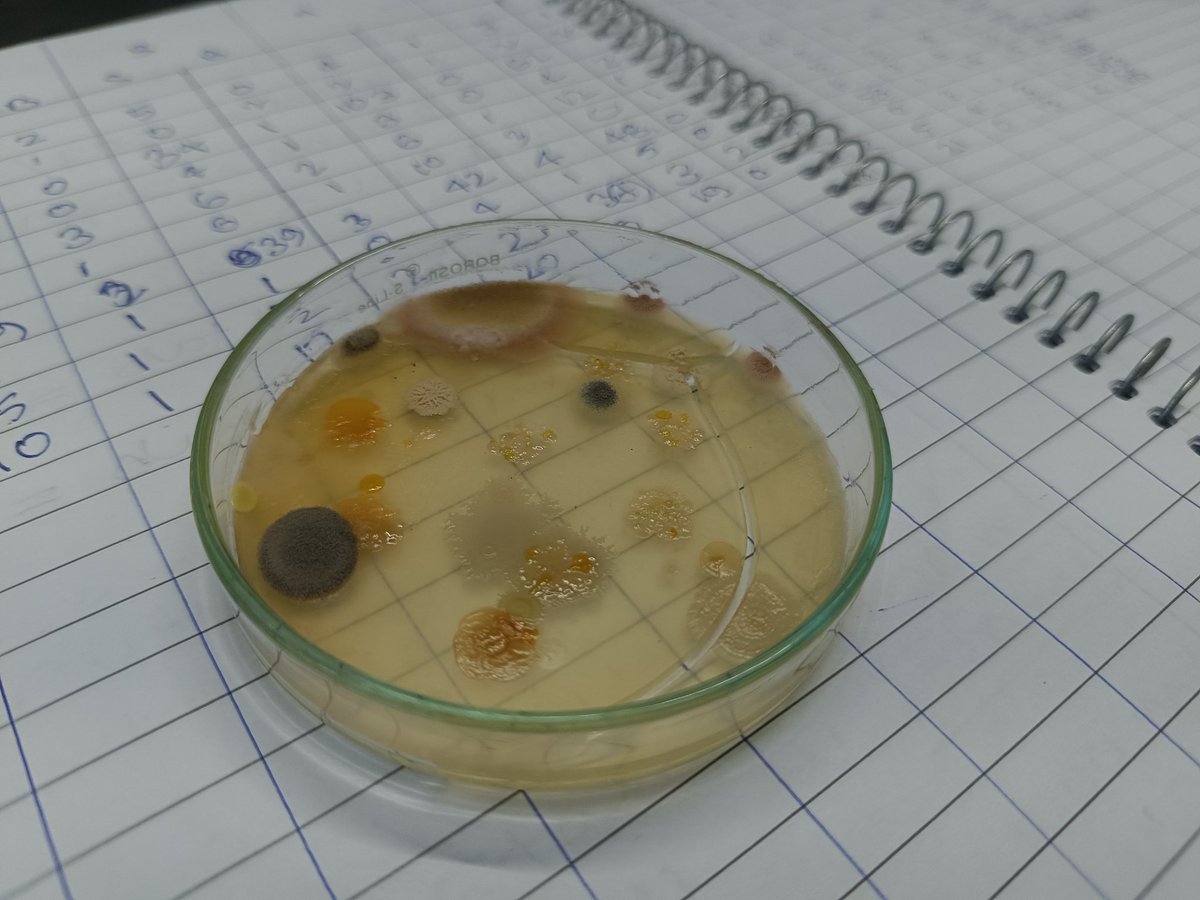
JishuHaldar2's tweet image. Spending my day in the lab, working on my final year project. Slow and steady progress—but it&apos;s happening! #PharmacyLife #LabDiaries #ResearchModeOn
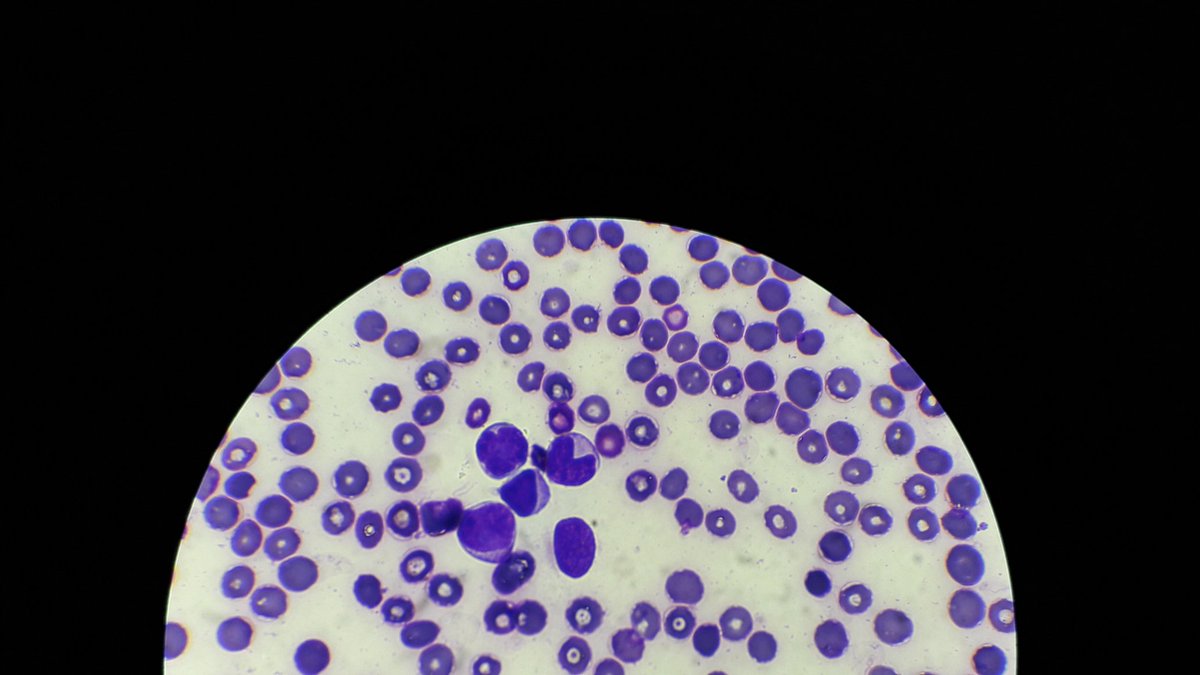
MedTechProblems's tweet image. Pati WBC, pinusuan ko na. 
#labdiaries

-ri💕
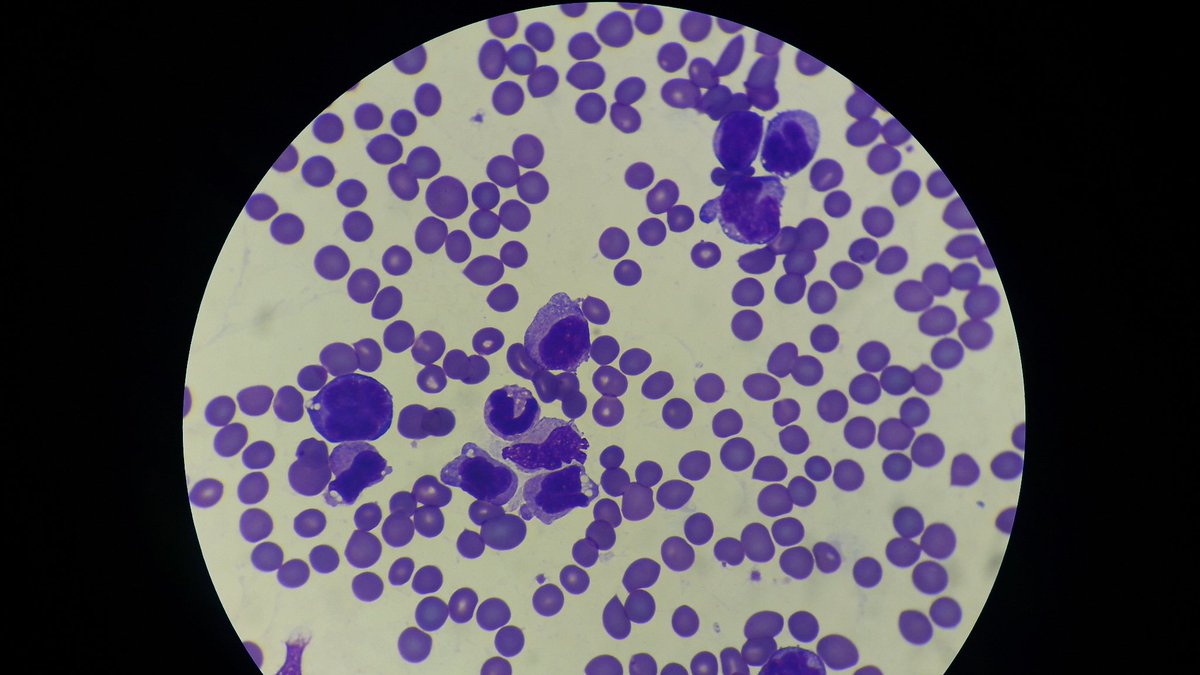
MedTechProblems's tweet image. 😱
#LabDiaries
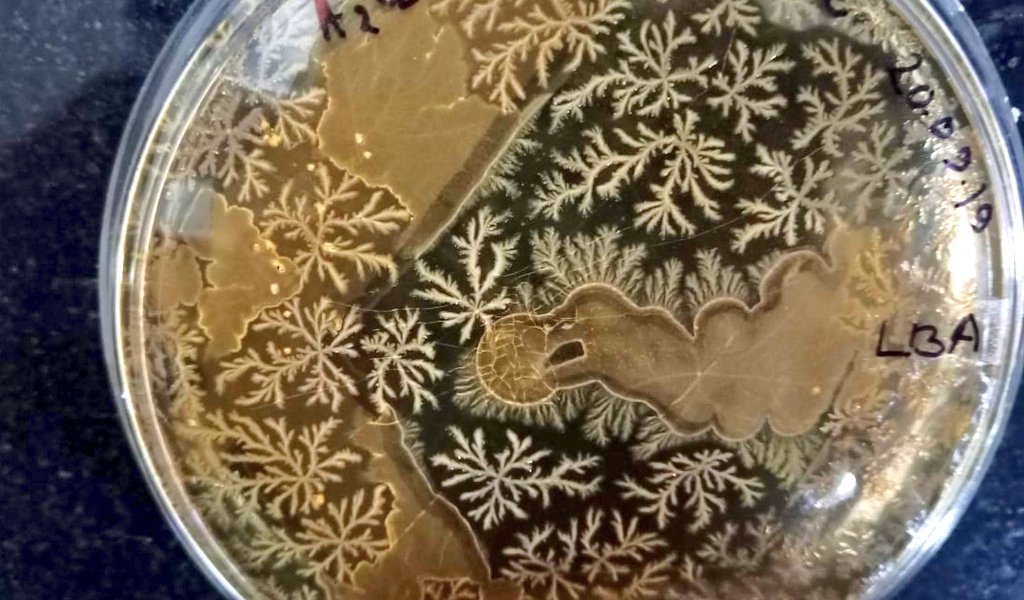
SanjitaPanigra2's tweet image. Bacteria Bacillus 😍😍😍
#labdiaries 
#Biotechnology
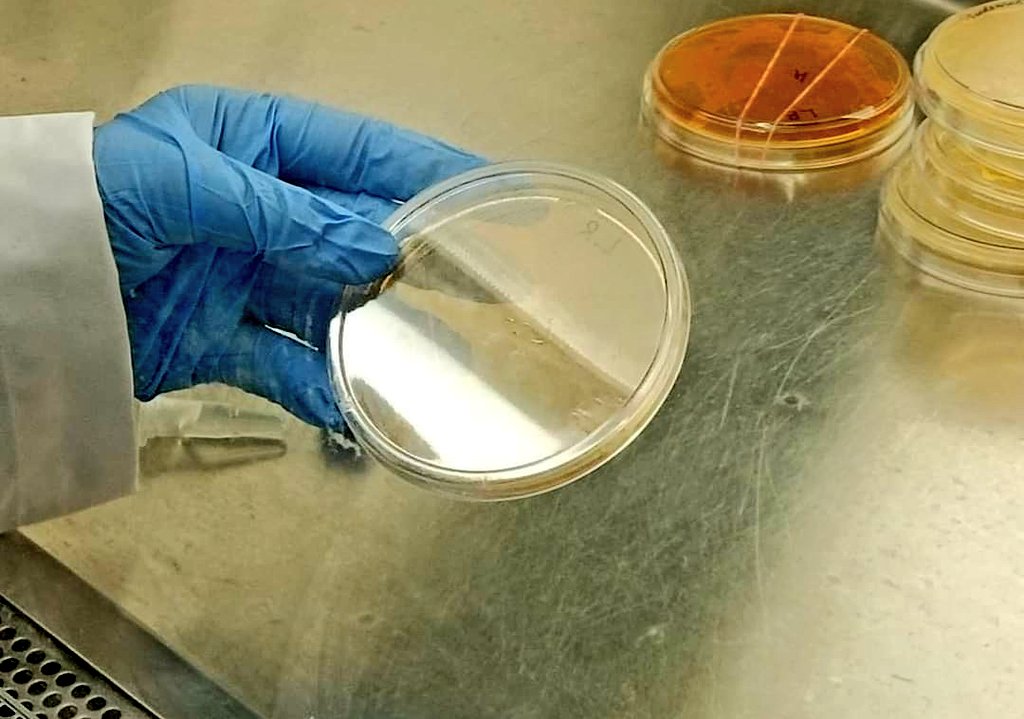
SanjitaPanigra2's tweet image. Diary Microbes.
#labdiaries

#labdiaries resultados da pesquisa
To most, it’s just a chaotic whiteboard full of scribbles. To us, it’s where ideas spark, evolve and turn into innovation. 🔬✨ Every scribble tells a story of discovery. #ResearchLife #Photonics #LabDiaries #ScienceInAction #Research #LabLife

Isolation of chromium resistance bacteria and detecting their environment. #labdiaries #Biotechnology

To most, it’s just a chaotic whiteboard full of scribbles. To us, it’s where ideas spark, evolve and turn into innovation. 🔬✨ Every scribble tells a story of discovery. #ResearchLife #Photonics #LabDiaries #ScienceInAction #Research #LabLife

Microprocessor lab mein woh 8085 kit pe code upload karte hi 'RAM error: 0x00FF' aa gaya. Kitna bhi reset karo, wahi. Meri toh lagta hai B.Tech bhi is kit ki tarah "memory corrupted" ho gayi hai. 😵💫 #LabDiaries #EngineeringLife
My C++ program for matrix multiplication gave a segmentation fault the moment HOD walked past my system. Bhai, it was working 2 seconds ago! Poore lab mein sirf mere system pe hi crash hona tha? Kismat hi kharab hai. 😵💫 #BTechStruggle #LabDiaries
Lab assistant ne bola mera circuit nahi chal raha kyunki 'electrons are feeling shy today'. Bhai, ye kaunsa syllabus hai? Mere 5 marks kat gaye 'electron shyness' ke chakkar mein. Sir, physics mein 'feelings' pe marks milte hain kya? 🤦♂️ #BTechStruggle #LabDiaries
That one friend who sprints to say “I’ll write the introduction!” every time there’s a publication ! like it’s the Olympics of doing the easiest part..🏃♂️📄 😂 #labdiaries #publications
Microprocessor lab mein code run kiya. Output mein 'Hello World!' aaya... but in *binary* digits. Sir bola, 'Wah, future of encrypted messages!' 😂 Bhai, mujhe bas ek LED blink karani thi. 🤦♂️ #LabDiaries #BTechStruggle
Last time I wore two gloves, I was heading for skiing. Never imagined l'd be wearing three gloves until the anaerobic chamber and its gut microbiota made the call😂 #labdiaries 🧪
C-lab ka viva tha. Code sahi chal raha tha 10 baar, ma'am ke aate hi segmentation fault! Poore campus mein meri badnaami ho gayi 'pointer guru' se 'null pointer' pe. Matlab why me?! 🤦♂️ #LabDiaries #CollegeLife
Aaj Microprocessor lab mein teacher ne output verify karne ke liye multimeter se CPU ke pins check karna shuru kar diya. Mera toh 8085 chip jalte-jalte bacha. Sir, debugging ka aur tareeka nahi? 💀 #EngineeringMemes #LabDiaries
Hamare Embedded Systems ke sir ne bola 'Bhai, yeh LED blink kar raha hai? Nahi kar raha na? Toh chhod de.' Phir pura practical file hi de diya without even checking. Kya matlab hum CSE wale soldering iron sirf paper pe hi dekhenge? 🫠 #LabDiaries #BTechStruggle
Our DLD prof just marked me down in lab for using a red wire for ground instead of black. Matlab colour coding ka viva chal raha hai ya circuit design ka? Meri toh fuse ud gayi. 🤯 #EngineeringMemes #LabDiaries
Ye C++ ka code mere laptop pe segmentation fault de raha tha 4 ghante se. Abhi lab mein sir ke saamne compile kiya, ekdum perfect run ho gaya! 🤯 Matlab, laptop ko bhi meri izzat ki padi hai? #BTechStruggle #LabDiaries
Some days, just showing up is an achievement. Tired, overwhelmed, but still showing up for the science. #GradLife #ResearchLife #LabDiaries #AcademicBurnout #ScienceHumor #LabJokes

Through Student Lens Where curiosity meets chemistry. From the garden to the paper- watch nature leave its mark! Experiments in progress at IITK... Courtesy: Mehek Agarwal Btech (Chemical Engineering) #labdiaries #chemicalengineering #iitk #IITK #natureexperiment…
Spending my day in the lab, working on my final year project. Slow and steady progress—but it's happening! #PharmacyLife #LabDiaries #ResearchModeOn

Day 2: DNA extraction continues! 🧬 Nanodrop gave us an A260/A280 of 3.1, so we’re likely looking at RNA contamination. Time to clean up and optimize our protocol! 🔬✨ #ScienceJourney #LabDiaries
Isn't beautiful 😍? #labdiaries

Chromium resistance bac. #biotechnology #labdiaries


Isolation of chromium resistance bacteria and detecting their environment. #labdiaries #Biotechnology

Isolation of chromium resistance bacteria and detecting their environment. #labdiaries #Biotechnology

Steam's good! It is also used in Conservation treatments such as removal of tapes and old repairs that have water soluble adhesives. The main equipment used for this was a steam pencil. #Conservation #labdiaries #mewar #rajasthan #udaipur #citypalaceudaipur #museum


Something went wrong.
Something went wrong.
United States Trends
- 1. Chris Paul 10.3K posts
- 2. Clippers 18.3K posts
- 3. FELIX LV VISIONARY SEOUL 16.4K posts
- 4. #FELIXxLouisVuitton 18.9K posts
- 5. Pat Spencer 2,749 posts
- 6. jungkook 242K posts
- 7. rUSD N/A
- 8. Good Wednesday 22K posts
- 9. Kerr 5,785 posts
- 10. Podz 3,369 posts
- 11. Lawrence Frank N/A
- 12. Shai 16.2K posts
- 13. Seth Curry 5,222 posts
- 14. Jimmy Butler 2,685 posts
- 15. Hield 1,621 posts
- 16. TOP CALL 9,660 posts
- 17. Carter Hart 4,226 posts
- 18. Brandy 8,544 posts
- 19. Earl Campbell 1,243 posts
- 20. #SeanCombsTheReckoning 5,694 posts